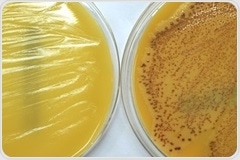
Genetic mutation appears to help people fight off MRSA

|
|
|
| |

|
|
| |
The latest Genetics news from News Medical |
|
|
|
 | | | Genetic mutation appears to help people fight off MRSA Genetic mutation appears to help people fight off MRSA Researchers have discovered that people who carry a certain genetic mutation may have a greater chance of fighting off MRSA infections. The study provides further insights into the genetic factors underlying predisposition to persistent MRSA infections and could help researchers develop more effective treatments. | |
|
|
| |  | | |  The heart of modern therapy is increasingly personalized and targeted at specific cellular or genetic deficits. This requires gene therapy, in many cases. A new study, published on 19 September 2019 in the journal Nature, describes an improved way to produce purified gene carrier viruses called AAVs cheaply and quickly, from the culture medium. The heart of modern therapy is increasingly personalized and targeted at specific cellular or genetic deficits. This requires gene therapy, in many cases. A new study, published on 19 September 2019 in the journal Nature, describes an improved way to produce purified gene carrier viruses called AAVs cheaply and quickly, from the culture medium. | | | | |  The heart of modern therapy is increasingly personalized and targeted at specific cellular or genetic deficits. This requires gene therapy, in many cases. A new study, published on 19 September 2019 in the journal Nature, describes an improved way to produce purified gene carrier viruses called AAVs cheaply and quickly, from the culture medium. The heart of modern therapy is increasingly personalized and targeted at specific cellular or genetic deficits. This requires gene therapy, in many cases. A new study, published on 19 September 2019 in the journal Nature, describes an improved way to produce purified gene carrier viruses called AAVs cheaply and quickly, from the culture medium. | | | | |  In an unprecedented scale, researchers have begun to unravel the genetics that may predispose some individuals to develop kidney disease once they have diabetes, independent of the degree of blood sugar control. In an unprecedented scale, researchers have begun to unravel the genetics that may predispose some individuals to develop kidney disease once they have diabetes, independent of the degree of blood sugar control. | | | | |  At the Association for Glycogen Storage Disease's 41st Annual Conference, Dr. David Weinstein of UConn School of Medicine and Connecticut Children's presented his groundbreaking, one-year clinical trial results for the novel gene therapy treatment for glycogen storage disease. At the Association for Glycogen Storage Disease's 41st Annual Conference, Dr. David Weinstein of UConn School of Medicine and Connecticut Children's presented his groundbreaking, one-year clinical trial results for the novel gene therapy treatment for glycogen storage disease. | |
|
|
|
|
|
|
|